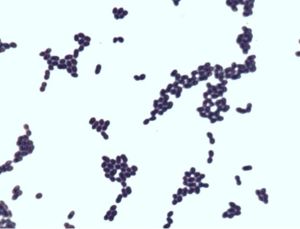
耐久腸球菌

基本信息
產品ID號:47134
產品編號:CL7032
中文名稱:耐久腸球菌ATCC6056
英文名稱:
產品規格:5支/包裝
產品類別:質控菌株>>Remel質控菌株
詳細信息
Culti-Loops質控菌株接種環為5支/包裝,除彎曲菌屬需冷凍保存(-18℃)外,其它都應在2-8℃保存。
D-鳥氨酸鹽酸鹽/(R)-2,5-二氨基戊酸單鹽酸鹽/D-氫氯鳥氨酸/D-OrnithineHCl
D-葡萄糖-1-磷酸二鈉/1-磷酸葡萄糖二鈉鹽/1-磷酸葡萄糖酸二鈉鹽/G-1-P-Na2
D-葡萄糖-6-磷酸單鈉鹽/β-D-葡萄糖-6-磷酸鈉鹽/6-磷酸葡萄糖鈉鹽/6-磷酸葡萄糖酸一鈉鹽/G-6-P-Na
簡介
菌落較小,圓形凸起,有光澤,菌體球形或卵圓形,常成對,成串出現;發酵果糖、葡萄糖、乳糖、麥芽糖、蔗糖、山梨醇、苷醇、水楊苷、纖維二糖、七葉苷、甘露糖等;不發酵蜜二糖、阿拉伯糖、棉子糖;耐4%和6.5%NaCl;45℃生長。